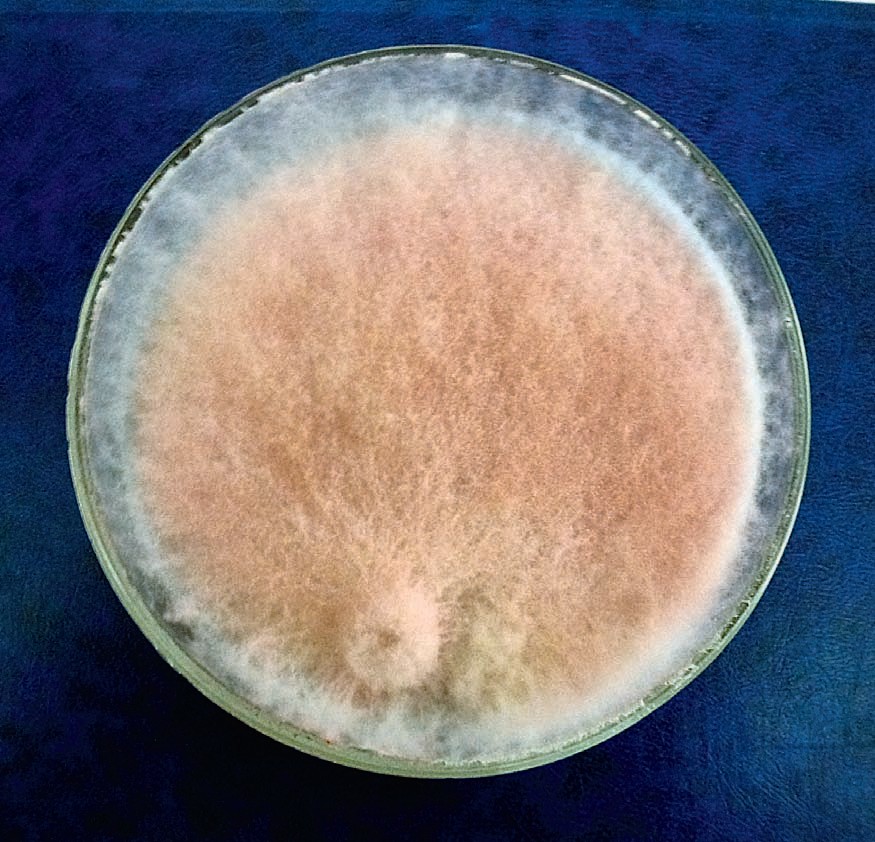

Крошечные стражи подземных галактик
Статья — победитель конкурса научно-популярных статей, проходившего в рамках XIII Всероссийской олимпиады «Нанотехнологии — прорыв в будущее!», организованной МГУ им. М. В. Ломоносова и ФИОП (группа РОСНАНО).

Корневые системы растений занимают в почве огромные пространства. Суммарная длина корней пшеницы без учёта корневых волосков, по разным данным, может достигать от 60—70 до 600 км! Если же учитывать корневые волоски (выросты клеток покровной ткани корня в зоне поглощения), которых на одном растении может быть до 14—15 млрд, то суммарная длина корней может достигнуть 10 000 км! Суммарная поверхность корней ржи, подсчитанная в одном из исследований, опять же без корневых волосков, составила 237 м2. Это примерно площадь теннисного корта.
Слой почвы толщиной около 2—5 мм, непосредственно прилегающий к поверхности корней и называемый ризосферой (от греч. rhiza — корень и sphaira — шар, сфера), обильно заселён микроорганизмами. Размеры бактерий составляют в среднем 0,5—3 мкм (10‒6 м), поэтому для них корневая система с указанной площадью поверхности составляет если не галактику, то целый континент размером, скажем, с Австралию. Естественно, что поверхность других органов растения — стеблей, листьев (филлосфера), цветов, плодов, семян (спермосфера) — также населяют микроорганизмы, но такого их обилия и разнообразия, как в прикорневой зоне, нет.
Ризосфера значительно отличается по своим свойствам от «свободной» почвы. Здесь на 1—2% выше влажность, несколько другая реакция среды (обычно если почва кислая или щелочная, то ризосфера ближе к нейтральной), выше содержание органических веществ, растворимость некоторых минеральных веществ, например соединений железа и марганца. Ризосфера — лакомая экологическая ниша (вернее, совокупность множества мини-экологических ниш) для почвенных обитателей — от микроскопических бактерий и грибов (и даже водорослей!) до червей всех типов и членистоногих.
Что же их так привлекает в этом узком участке почвы? В первую очередь корневые выделения. Физиология растений такова, что до 20—25% усвоенного ими в процессе фотосинтеза углерода теряется с корневыми выделениями. Причём это не только пассивные потери, а по большей части активная секреция корнем различных веществ. То есть корень не только орган поглощения воды и минералов, но и орган синтеза и переработки веществ. Например, органические кислоты, выделяемые корнем, повышают растворимость соединений фосфора, кальция и железа в почве, делая их более доступными для усвоения растением. Многие низкомолекулярные соединения корневых выделений могут подавлять рост других растений-конкурентов или фитопатогенов. Эти вещества называют фитонцидами.
Есть вещества, которые выделяются при естественном отмирании корней, «слущивании» корневых чехликов и т. д.
Несмотря на кажущуюся расточительность растений, такие траты вполне оправдывают себя. Для микроорганизмов ризосфера благодаря корневым выделениям — источник легкоусвояемых органических веществ. Это, прежде всего, сахара — глюкоза, фруктоза, мальтоза и др., и органические кислоты — например яблочная, лимонная, янтарная, а также аминокислоты, витамины и др. Всё это очень быстро поглощается и перерабатывается для своих нужд теми представителями почвенной микробиоты, которые оказались самыми «расторопными» и сумели заселить прикорневые зоны быстрее других.
Но какой толк от этого растению? Если в почве небольшое содержание спор и клеток болезнетворных грибов и бактерий (невысокий инфекционный фон), то при благоприятных погодных условиях ризосфера растения заселяется преимущественно дружественными микроорганизмами. Теми, которые не агрессивны к нему, не претендуют на его клетки и ткани, а, наоборот, в обмен на «стол и дом» оказываются полезными ему в меру своих не столь малых, как может показаться, сил. Такие микроорганизмы, которые стимулируют рост растений, называются PGPR-бактериями (Plant Growth Promoting Rhizo bacteria). Наиболее часто встречаются PGPR-штаммы среди родов Psеudomonas, Bacillus, Azospirillum, Azotobacter, Clostridium, Enterobacter, Klebsiella и др.
Агенты PGPR, как и любые другие суперагенты, обладают суперспособностями. Они быстро и эффективно заселяют (колонизируют) ризосферу, интенсивно размножаются и увеличивают свою численность в ней; устойчивы к неблагоприятным факторам внешней среды — колебаниям температуры, рН почвы, влажности и т. д. Эти микроорганизмы усваивают не только легко доступные корневые выделения, но и разнообразные питательные субстраты; при этом они улучшают минеральное питание растения-хозяина, защищают его от патогенных микроорганизмов.
PGPR не только быстро заселяют ризосферу, но и успешно удерживают завоёванные позиции от посягательств других колонизаторов. Например, фитопатогенных грибов, которые при контакте с корнем разрушают его покровы, проникают во внутренние ткани (паренхиму), поражают проводящую систему (сосуды и ситовидные трубки) и способны распространяться выше по стеблю вплоть до генеративных органов (цветов и плодов). Фитопатогенные грибы повинны, например, в таких заболеваниях корней растений, как корневые гнили, «чёрная ножка», «снежная плесень», полегание сеянцев, увядание и т. д. Корни, поражённые фитопатогенными грибами, темнеют, становятся склизкими, легко разрушаются, приобретают неприятный запах. Всё это объясняется действием ферментов и токсинов грибов, разрушающих клеточные стенки и мембраны растительных клеток. Высвобождающееся содержимое клеток становится субстратом для развития и жизнедеятельности патогенов. Поэтому их называют зловещим словом — некротрофы, то есть питающиеся мёртвым.
